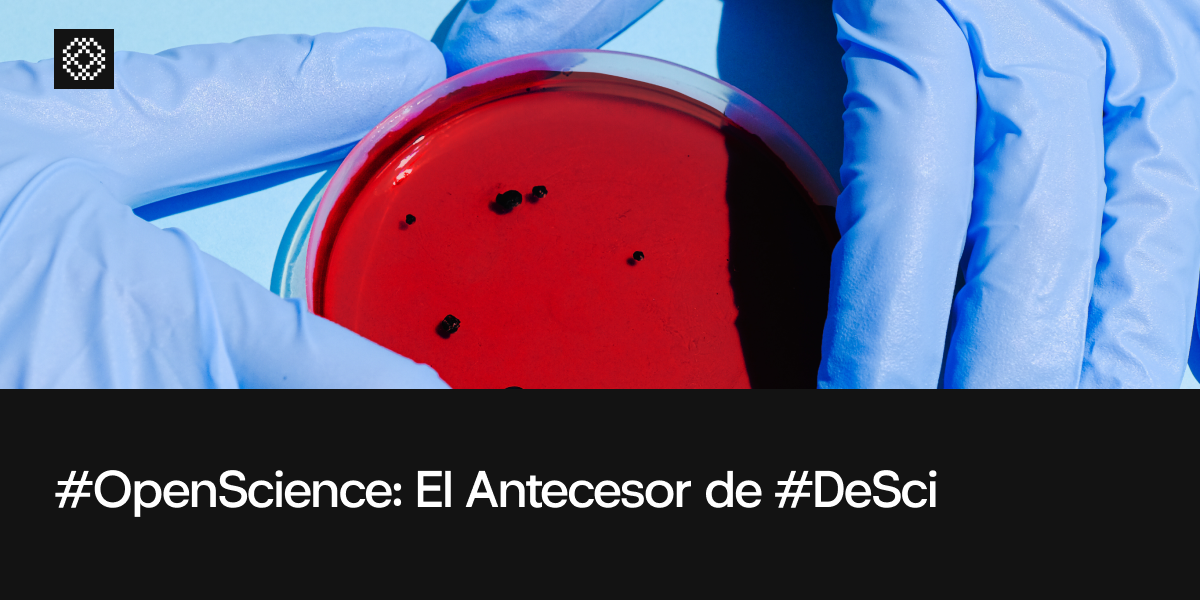

Encontrando una cura para la fiebre amarilla con ViralCure.org – DeSciReport
]]>La fiebre amarilla es una enfermedad bastante común en zonas tropicales de Sudamérica y África. Puede ser mortal para las personas no vacunadas y sigue siendo una amenaza para quienes viven en zonas endémicas.